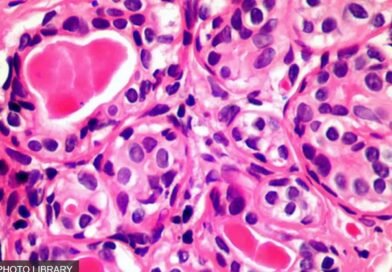
Image de cellules cancéreuses

- Pourquoi la solitude explose en France : le grand malaise silencieux de 2026
- TikTok et politique française : la nouvelle bataille de l’influence
- Triangle Borea BR02 Connect : l’enceinte active qui réconcilie audiophiles et amoureux du design
- Aladdin : la marque Caviar transforme un robot humanoïde en œuvre d’art à plus de 100 000 $
- Affaire Epstein : plusieurs personnalités françaises apparaissent dans les nouveaux documents
POLITIQUE

TikTok et politique française : la nouvelle bataille de l’influence
La politique française connaît une transformation profonde. Pendant des décennies, la télévision, la presse écrite et les grands débats télévisés
SANTÉ

Un rapport de la CIA relance le débat sur la recherche contre le cancer
Un document déclassifié provenant des archives de la Central Intelligence Agency (CIA) attire depuis peu l’attention du public et des
ECONOMIE

Orange Bank ferme sa banque
Après les faillites des banques américaines en 2023, la banque en ligne Orange Bank, filiale du célèbre opérateur téléphonique, va supprimer
INTERNATIONAL

Trump inaugure sa seconde Présidence avec une rafale de décrets exécutifs
Le 20 janvier 2025, le président Donald Trump a marqué son retour à la Maison Blanche avec une série de décrets exécutifs, signalant une volte-face par rapport aux politiques de son prédécesseur. Ces décrets, visibles sur le site officiel de la Maison Blanche, reflètent une volonté de réorienter l’agenda politique des États-Unis. Cet article explore en profondeur les implications de ces actions, analysant leur impact potentiel sur divers aspects de la société américaine et internationale.
FRANCE

Nouvelle règlementation française sur l’importation de cigarettes en UE
Dans un retournement majeur de la politique française, le quota d’importation de cigarettes pour les particuliers voyageant depuis l’Union européenne
LIFESTYLE

KD11 : La chaussure de basketball Nike pour une foulée fluide et dynamique
Lancée sur le marché avec une campagne impressionnante, la KD11 de Nike représente le summum de l’innovation dans les chaussures
TOP VIDEOS

On vous ment sur le livret A
Excellente vidéo de la chaîne YouTube “Libre & Riche” qui vous explique les raisons pour lesquelles l’Etat français vous vole